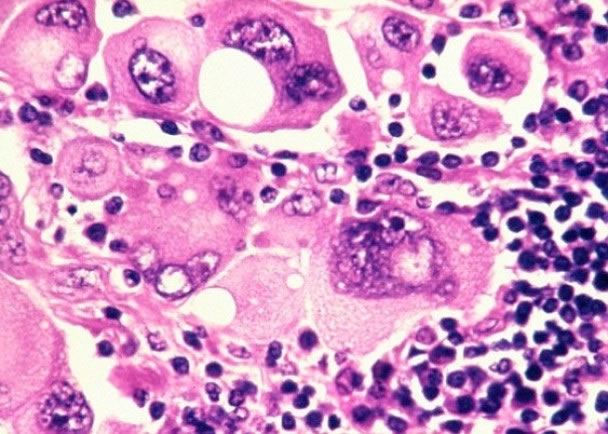
专家指长期接触紫外线可能增加罹患皮肤癌的风险

手机平板电脑会反射紫外线 长期户外使用可能增加罹患皮肤癌危险
智能手机或平板电脑的萤幕会反射紫外线
专家指长期接触紫外线可能增加罹患皮肤癌的风险
(蜘蛛网报道)多用智能手机或平板电脑,除了可能影响视力,美国最新研究发现,这还会增加患皮肤癌的风险,原因是电子产品的萤幕会反射紫外线,长期在户外使用,可能增加用家罹患皮肤癌的危险。
美国新墨西哥州大学的研究员,利用不同的电子产品进行2轮实验,以量度吸收了多少紫外线。在首轮中,研究员先以人体模型戴上紫外线探测器,再把产品置于较远的16.5吋距离,结果显示,在早上11时至中午12时的一个小时内,美国苹果公司的iPad2会令模型吸收多8成半的紫外线,11吋大的Macbook亦有7成半。在第2轮测试中,研究员把iPhone5放在人体模型12.25吋外位置,结果亦增加3成6紫外线吸收。
由于紫外线的影响可以累积在人体内,专家建议,民众在户外使用这些电子产品时,最好先做足预防措施,如涂上太阳油、戴上太阳眼镜、保护脸部及颈项等,以减低患皮肤癌的机会。